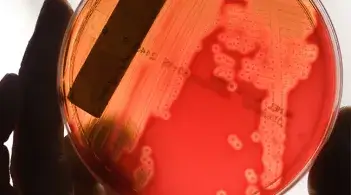

Experts believe that one-third to one-half of all cancers can be prevented. Cancer Prevention
Priority Cancer Campaigns
Skin Cancer
Did you know that Vermont has the third highest incidence rate of melanoma in the country?
You can prevent most skin cancers by practicing Sun Safety.
Lung Cancer
Lung cancer is the #1 cause of cancer deaths. If you are 50-80 years old, smoke cigarettes or quit in the last 15 years, and have smoked at least 20 pack-years, you should talk to your doctor about lung cancer screening.
Colorectal Cancer
Colorectal cancer is the second leading cause of cancer-related deaths in the country, yet it is highly preventable with screening. Screening for colorectal cancer starts at age 45 for average-risk, asymptomatic people.
Learn more about colorectal cancer.
Prostate Cancer
Other than skin cancer, prostate cancer is the most common cancer in men in the country. About 1 in 8 men will be diagnosed with prostate cancer during their lifetime.
Breast Cancer
Breast cancer has the highest cancer incidence rate in our catchment area. Early detection through regular screenings can help to find and treat breast cancer early, leading to better outcomes.
HPV Cancers
HPV is a virus that can cause 6 different types of cancer. The HPV vaccine can prevent over 90% of these cancers when given at the recommended ages.
Learn more about cancers linked with HPV and HPV prevention.